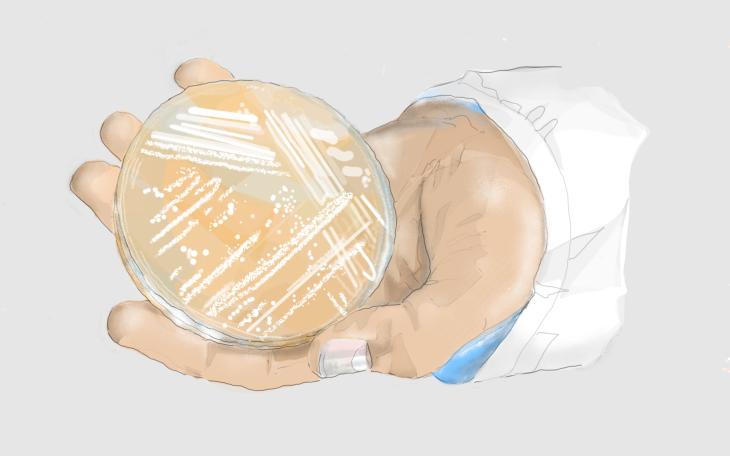

Aspergillose
Aspergillose, wenn es zu einer Schimmelpilz-Infektion der Schlauchpilz-Gattung (Aspergillus) kommt.
Mediziner können somit schnell und einfach ihr Wissen teilen.
Der Text wird ärztlich validiert, aktualisiert und darf für Forschung/Training genutzt werden.